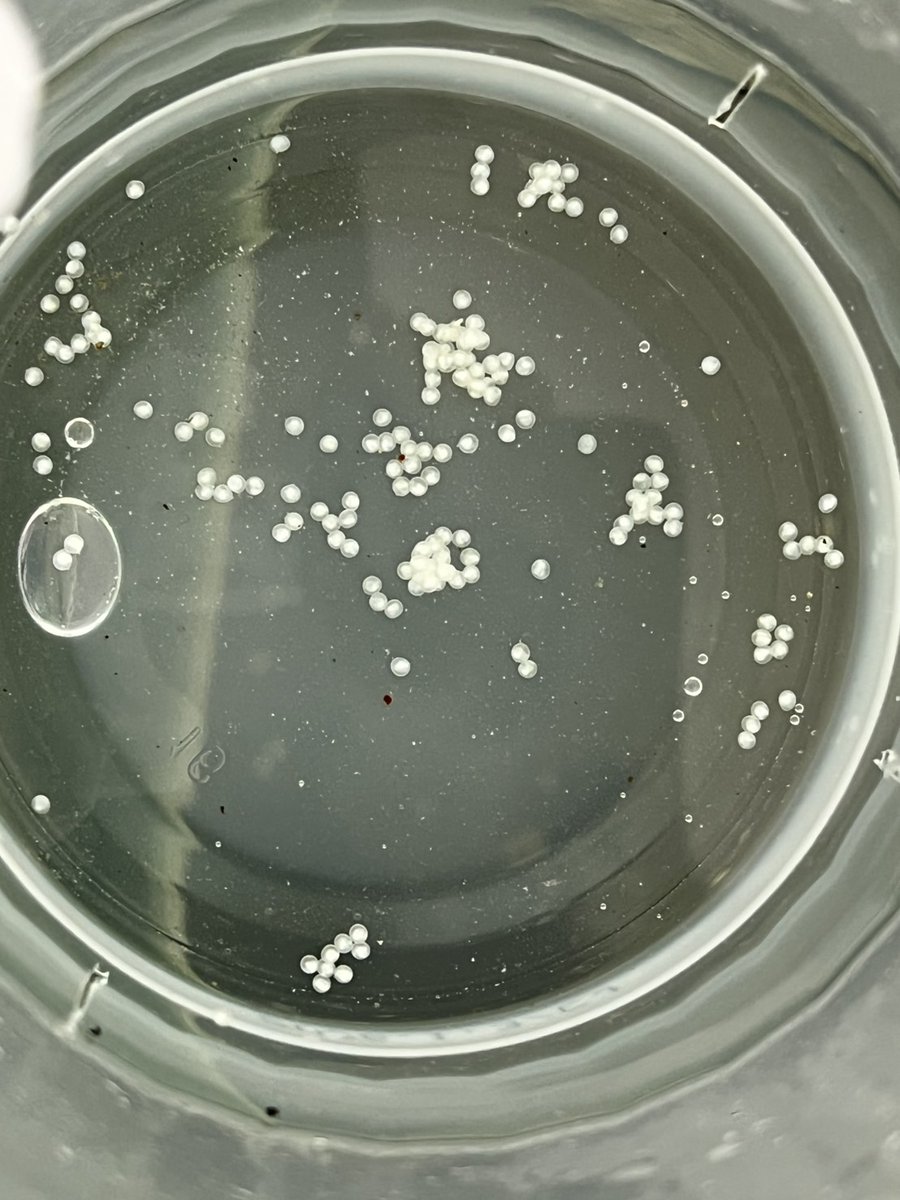
NetShopNEOS's tweet image. また！！！！！
卵！！！！！
産んでくれてました！！！！！
…白いなぁ……

でも、産んでもらえる環境ということでうれしく思います！！

ネオス公式/小動物用品も扱ってます🐶
@NetShopNEOS
熱帯魚やアクア用品を販売しているネオスです!最近では小動物の用品も始めました🐈 セール情報や入荷の情報をお届けします( ´∀` ) YouTube→http://x.gd/a7ltn Instagram→http://x.gd/rDwYG お問い合わせ→[email protected]
You might like
本日20時からsale始まります! (20時前は見れない可能性あります) ↓下記URLです↓ 楽天 rakuten.ne.jp/gold/fish-neos… ・ヤフー shopping.geocities.jp/fish-y/sale/20… 1点物が増えているかも… 是非セールページだけでも見てください! よろしくお願いいたします!

また!!!!! 卵!!!!! 産んでくれてました!!!!! …白いなぁ…… でも、産んでもらえる環境ということでうれしく思います!!
プレゼント企画をするにあたって、DMを公開したのですが毎日毎日スパム?と思われるものが届きます。 速攻通報&ブロックしています。 ご容赦ください。
セール延長! 楽天 rakuten.ne.jp/gold/fish-neos… ヤフー shopping.geocities.jp/fish-y/sale/20… 本日11時から予定です!

なんと!!! 本日01:59分に終了しました”スーパーセール” 好評の為… 🎊セール期間延長します!!!🎊 期間は 2025年9月11日11:00(予定)~ 2025年9月24日10:00 です!!! 是非、買い忘れた…などあった方、この機会にお買い求めいただければと思います! よろしくお願いいたします!
只今セール期間中です! 1点物の生体やお買い求め易くなっている”日曜闇市”の用品も追加されております! 是非ページだけでも見て頂ければと思います! よろしくお願いいたします!
本日20時からsale始まります! (20時前は見れない可能性あります) ↓下記URLです↓ 楽天 rakuten.ne.jp/gold/fish-neos… ・ヤフー shopping.geocities.jp/fish-y/sale/20… 1点物が増えているかも… 是非セールページだけでも見てください! よろしくお願いいたします!

本日20時からsale始まります! (20時前は見れない可能性あります) ↓下記URLです↓ 楽天 rakuten.ne.jp/gold/fish-neos… ・ヤフー shopping.geocities.jp/fish-y/sale/20… 1点物が増えているかも… 是非セールページだけでも見てください! よろしくお願いいたします!

カテゴリ整理の関係で商品を探しづらい・見つけづらい状況になっています。 お手数おかけいたしますが、2つのカテゴリを確認していただけたらと思います。 よろしくお願いいたします。



おはようございます! やっぱり卵はカビてしまいました… でも、アドバイスをくれた方々のおかげで”白い卵は…” と学ぶことができました! これからも従業員に出来ることは頑張っていきたいと思います!
また!!! 卵が!!! …でもこれは、白いですね……… ってことは… ともあれ、産んでくれて従業員はうれしいです!

明日9/3日20時から!!! sale始まります!(プレから参加します) 期間は 2025年9月3日20時~ 2025年9月11日01:59分です! 是非セールページだけでも見て頂ければと思います!

おはようございます! 最近体調が思わしくないのか、ネコを抱っこしただけでアレルギー反応が出るようになってしまいました😭 痒いし鼻水は出るし喉はイガイガします…😭 皆さんも体調に気を付けてお過ごしください!!
う~ん… やっぱり卵カビてきてしまいました… 管理が悪いのか、水質か、無精卵なのか… 有精卵でもカビることがあるとか、調べてみましたが従業員には難しかったかもしれません😭
また!!!!!! たまご!!!!!!! 生まれて!!!!!! ました!!!!! 有精卵かな!!!!!?

あ… 卵… 食べられちゃってました… 他にカップで保管してるやつも… いくつかカビて、真っ白に… 無精卵だったのかな…
一点物のコリドラスちゃんが!!! なんと!!! 卵を産みました!!!!!!!! 従業員も初めて生で見て大興奮です!!!!! 有精卵か無精卵か今のところ分かりませんが、1週間ほどで孵るそうなので様子を見ていこうと思います!!!!!

United States Trends
- 1. 1.3 SOL N/A
- 2. Good Friday N/A
- 3. #FanCashDropPromotion N/A
- 4. #สนามอ่านเล่น2026xJimmySea N/A
- 5. JS AVOCEAN FAM SIGN N/A
- 6. #FridayVibes N/A
- 7. #ราคีTHESTAIN N/A
- 8. Happy Friyay N/A
- 9. #FridayMotivation N/A
- 10. RED Friday N/A
- 11. Hire Americans N/A
- 12. Christ Jesus N/A
- 13. MEET DAY N/A
- 14. Autopilot N/A
- 15. National Pie Day N/A
- 16. Cudi N/A
- 17. Ari Lennox N/A
- 18. Robbo N/A
- 19. Chargers OC N/A
- 20. March for Life N/A
You might like
-
 𝘔𝘢𝘮𝘦𝘥𝘢𝘯𝘨𝘰
𝘔𝘢𝘮𝘦𝘥𝘢𝘯𝘨𝘰
@bQ2OQ1E0Og14292 -
 ひろじい@アクアリウム
ひろじい@アクアリウム
@hrjaqua8 -
 T2 AQUA STYLE
T2 AQUA STYLE
@t2_aqua -
 45cmスリム水槽
45cmスリム水槽
@Anubias77 -
 ユーアクア
ユーアクア
@yu_aqua121 -
 モリオーネ美術水族館
モリオーネ美術水族館
@moriohne2022 -
 ヤマト/アクアリスト
ヤマト/アクアリスト
@yamato0704aqua -
 𝙈𝙄𝙏𝙎𝙐
𝙈𝙄𝙏𝙎𝙐
@mitsubrand -
 🌸桜花天昇🌸子育て中のおじさんです。
🌸桜花天昇🌸子育て中のおじさんです。
@YKUxP2voHyLPJvp -
 キャラちゃん(アクア託)
キャラちゃん(アクア託)
@ouMnPOkHFida4Bp -
 らびおり
らびおり
@rabiori_hanabi -
 nonoあくあ垢
nonoあくあ垢
@Betakatu -
 身の丈アクアリウム(みのアク)
身の丈アクアリウム(みのアク)
@e90_xc60 -
 Odeco
Odeco
@Odeco_aqua -
 IDLER
IDLER
@idler_aqua
Something went wrong.
Something went wrong.

















































![Lock_Shrimp's profile picture. ドーモ、カギエビです。
絵を描く陸棲十脚類でニンジャヘッズ。つまりニンジャで化け物だからおまえより強い。
悪堕ちアクアリウム狂人。植物も好き。
Pixiv[ https://t.co/NHwlyw0e1T]悪質な本物[@KEYSHRIMP_AQUA]
Do Not Re-Upload.](https://pbs.twimg.com/profile_images/2003022848856915969/DQIKepvL.jpg)

















































































